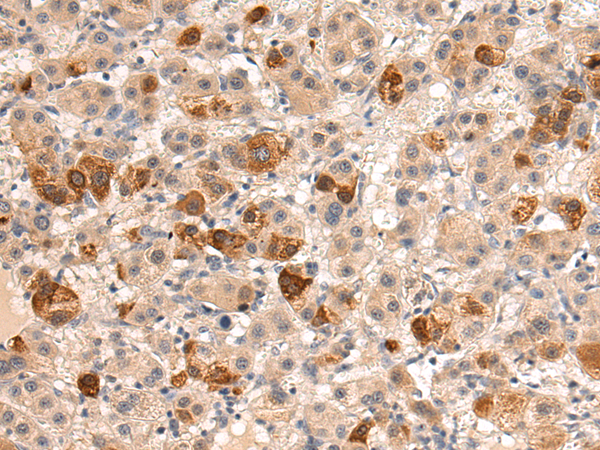

-
分类: 科研抗体货号: P04027别名: HMG-R, HMGIY, HMGA1A应用: IHC反应种属: Human, Mouse, Rat
-
分类: 科研抗体货号: P03965别名: BNAS2, CKLFSF3应用: WB,IHC反应种属: Human, Mouse
-
分类: 科研抗体货号: P03901别名: SEK, HEK8, TYRO1应用: IHC反应种属: Human, Mouse
-
分类: 科研抗体货号: P04021别名: HINT4应用: WB,IHC反应种属: Human
-
分类: 科研抗体货号: P03961别名: CKLFSF7应用: IHC反应种属: Human
-
分类: 科研抗体货号: P03900别名: EPH, EPHT, EPHT1应用: IHC反应种属: Human, Mouse
-
分类: 科研抗体货号: P04017别名: ERG1, HERG, LQT2, SQT1, HERG1, Kv11.1应用: WB反应种属: Human, Mouse, Rat
-
分类: 科研抗体货号: P03958别名: GASR, CCK-B, CCK2R应用: WB反应种属: Human, Mouse, Rat
-
分类: 科研抗体货号: P03889别名: ED4; PRR; HIgR; HV1S; HVEC; OFC7; PRR1; PVRR; CD111; PVRL1; PVRR1; SK-12; CLPED1; nectin-1应用: IHC反应种属: Human, Mouse
-
分类: 科研抗体货号: P04011别名: GRM1A, mGlu1, GPRC1A, MGLUR1, SCAR13, MGLUR1A应用: WB,IHC反应种属: Human, Mouse, Rat

鄂公网安备42018502007531号
鄂公网安备42018502007531号

